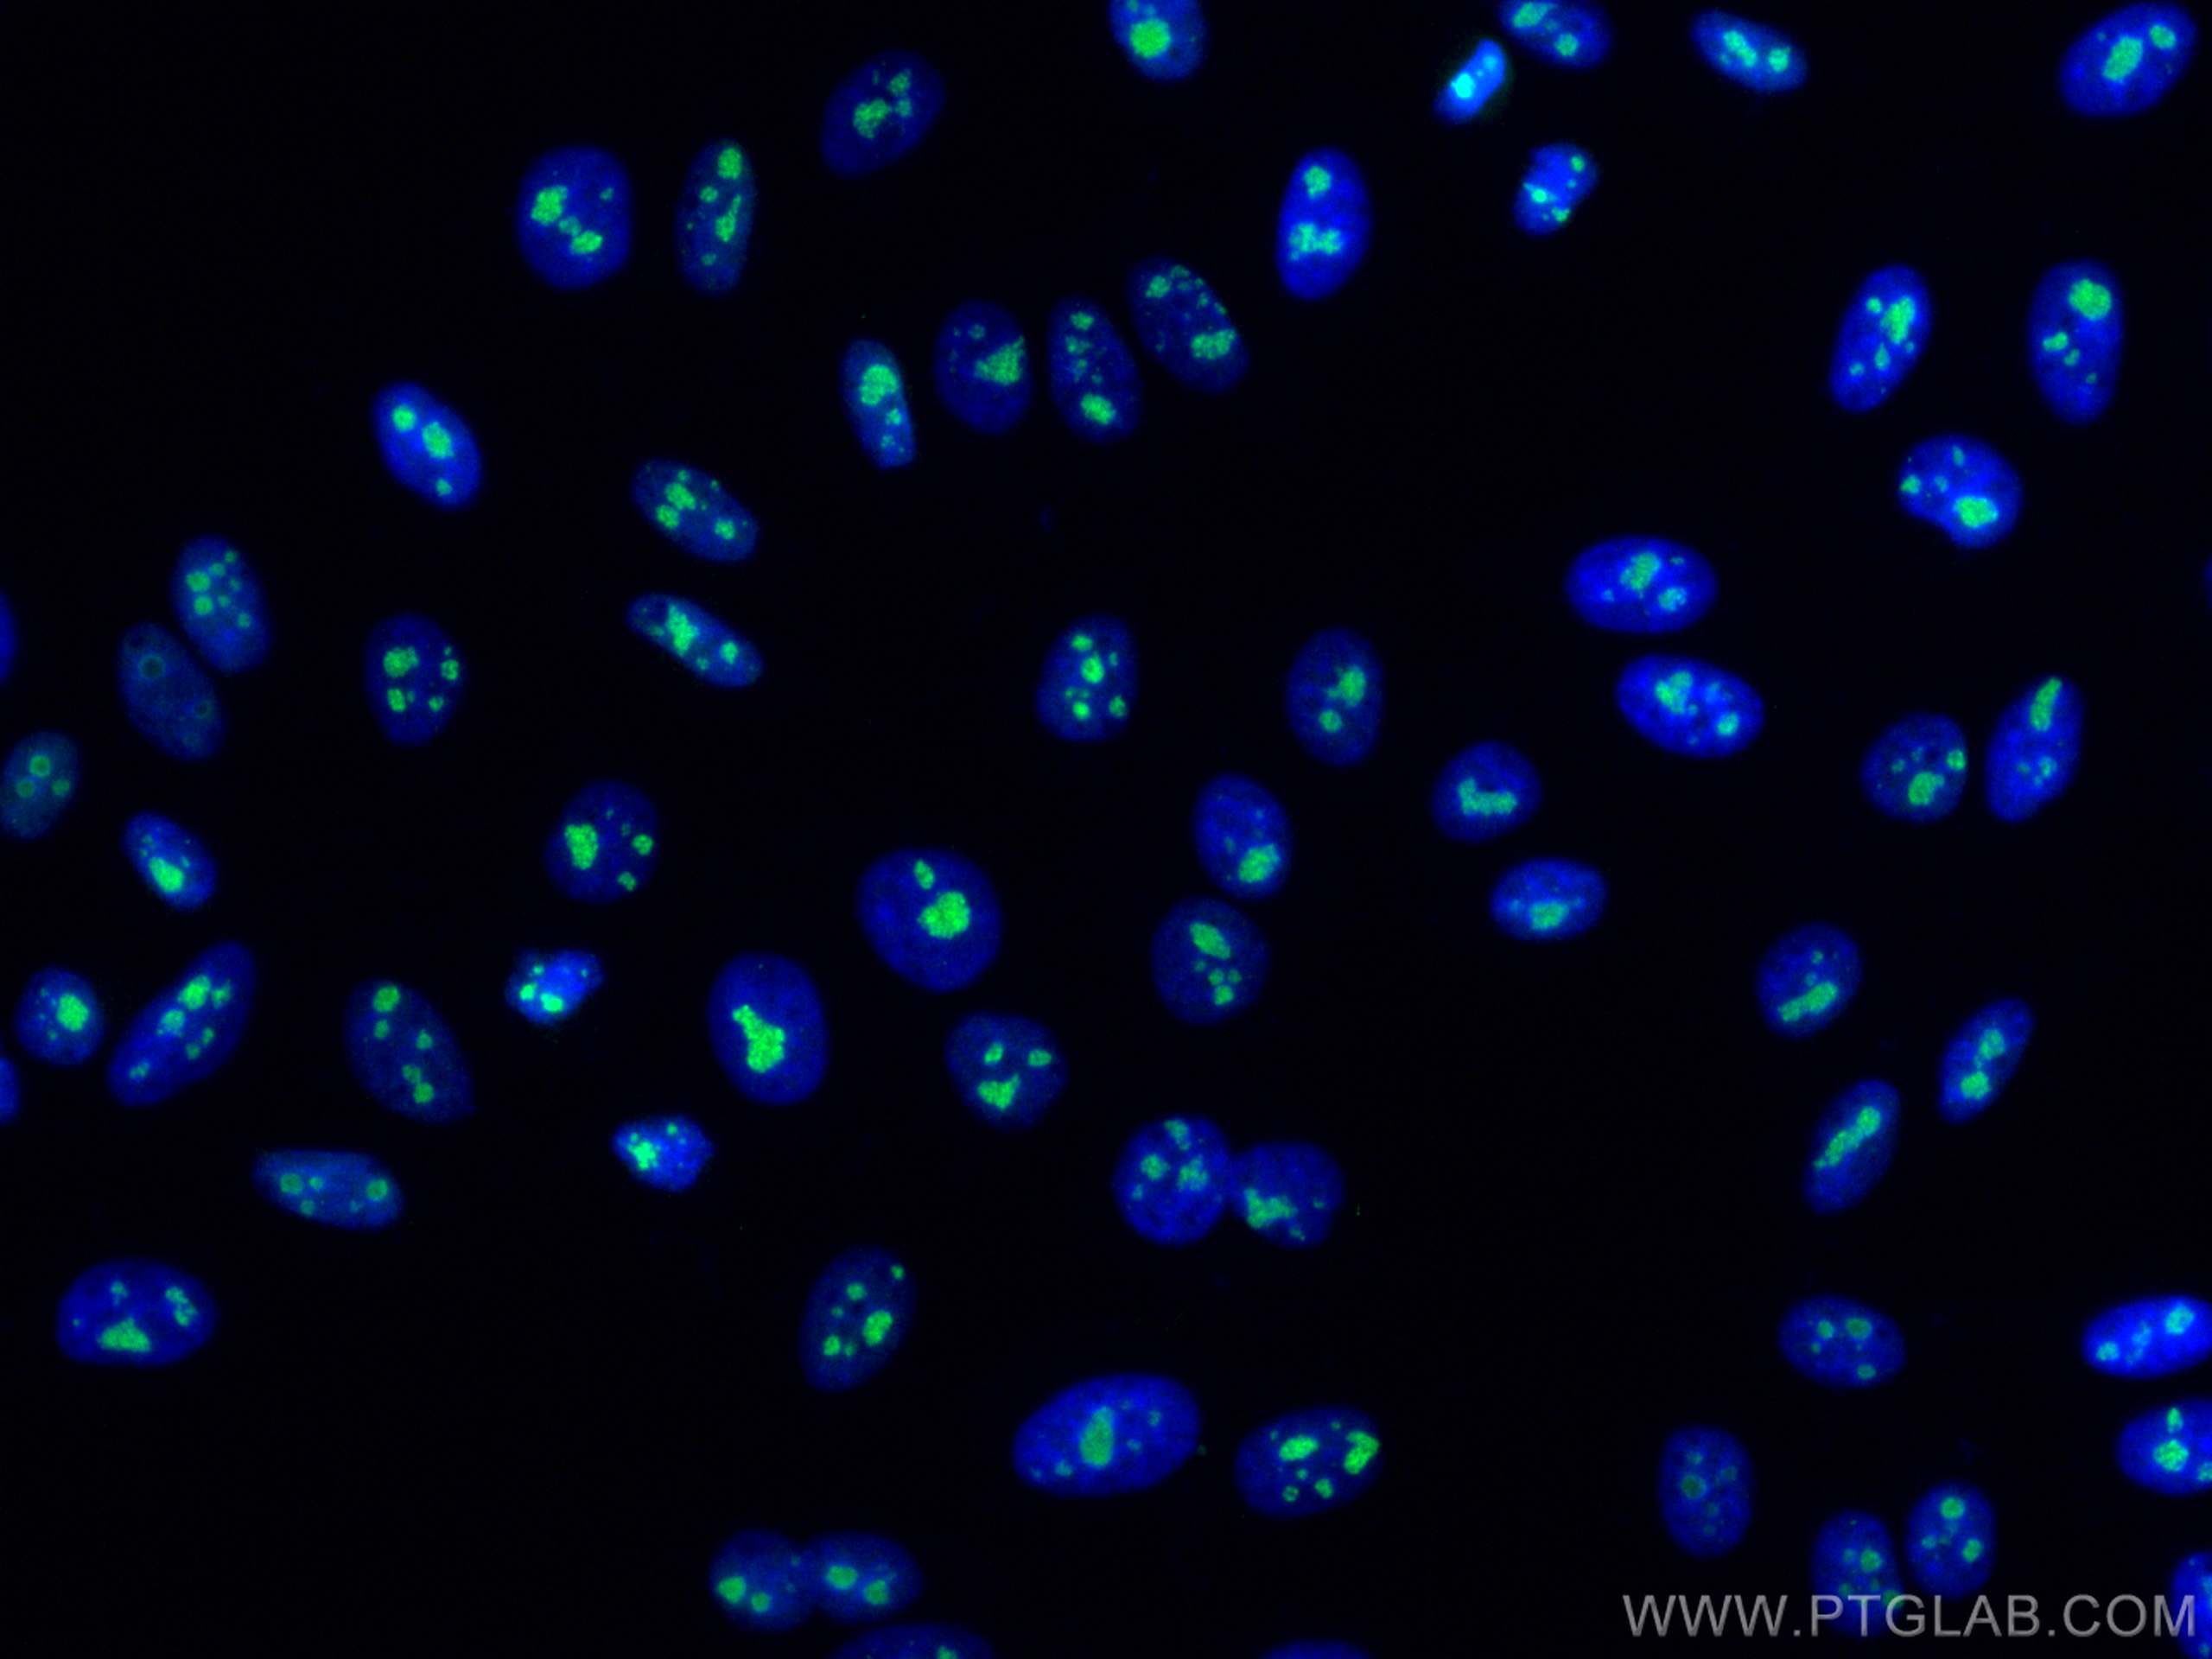

验证数据展示
经过测试的应用
| Positive WB detected in | HeLa cells, HEK-293 cells, HepG2 cells, Jurkat cells, HSC-T6 cells, NIH/3T3 cells, 4T1 cells |
| Positive IP detected in | HeLa cells |
| Positive IHC detected in | human liver cancer tissue Note: suggested antigen retrieval with TE buffer pH 9.0; (*) Alternatively, antigen retrieval may be performed with citrate buffer pH 6.0 |
| Positive IF/ICC detected in | HeLa cells, HepG2 cells |
| Positive FC (Intra) detected in | HepG2 cells, HeLa cells |
推荐稀释比
| 应用 | 推荐稀释比 |
|---|---|
| Western Blot (WB) | WB : 1:5000-1:50000 |
| Immunoprecipitation (IP) | IP : 0.5-4.0 ug for 1.0-3.0 mg of total protein lysate |
| Immunohistochemistry (IHC) | IHC : 1:1000-1:4000 |
| Immunofluorescence (IF)/ICC | IF/ICC : 1:200-1:800 |
| Flow Cytometry (FC) (INTRA) | FC (INTRA) : 0.40 ug per 10^6 cells in a 100 µl suspension |
| It is recommended that this reagent should be titrated in each testing system to obtain optimal results. | |
| Sample-dependent, Check data in validation data gallery. | |
产品信息
66985-1-Ig targets Fibrillarin in WB, IHC, IF/ICC, FC (Intra), IP, RIP, ELISA applications and shows reactivity with human, mouse, rat samples.
| 经测试应用 | WB, IHC, IF/ICC, FC (Intra), IP, ELISA Application Description |
| 文献引用应用 | WB, IF, RIP |
| 经测试反应性 | human, mouse, rat |
| 文献引用反应性 | human |
| 免疫原 |
CatNo: Ag8841 Product name: Recombinant human FBL protein Source: e coli.-derived, PET28a Tag: 6*His Domain: 1-321 aa of BC019260 Sequence: MKPGFSPRGGGFGGRGGFGDRGGRGGRGGFGGGRGRGGGFRGRGRGGGGGGGGGGGGGRGGGGFHSGGNRGRGRGGKRGNQSGKNVMVEPHRHEGVFICRGKEDALVTKNLVPGESVYGEKRVSISEGDDKIEYRAWNPFRSKLAAAILGGVDQIHIKPGAKVLYLGAASGTTVSHVSDIVGPDGLVYAVEFSHRSGRDLINLAKKRTNIIPVIEDARHPHKYRMLIAMVDVIFADVAQPDQTRIVALNAHTFLRNGGHFVISIKANCIDSTASAEAVFASEVKKMQQENMKPQEQLTLEPYERDHAVVVGVYRPPPKVKN 种属同源性预测 |
| 宿主/亚型 | Mouse / IgG1 |
| 抗体类别 | Monoclonal |
| 产品类型 | Antibody |
| 全称 | fibrillarin |
| 别名 | FBL, 3A9E8, EC:2.1.1.-, FIB, FIB1 |
| 计算分子量 | 321 aa, 34 kDa |
| 观测分子量 | 34 kDa |
| GenBank蛋白编号 | BC019260 |
| 基因名称 | FBL |
| Gene ID (NCBI) | 2091 |
| RRID | AB_2882303 |
| 偶联类型 | Unconjugated |
| 形式 | Liquid |
| 纯化方式 | Protein G purification |
| UNIPROT ID | P22087 |
| 储存缓冲液 | PBS with 0.02% sodium azide and 50% glycerol, pH 7.3. |
| 储存条件 | Store at -20°C. Stable for one year after shipment. Aliquoting is unnecessary for -20oC storage. |
背景介绍
Fibrillarin (Fbl) is an essential nucleolar protein that plays an essential role in ribosome biogenesis and more particularly in the methylation of ribosomal RNAs and rDNA histones. FBL is highly expressed in various cancers and correlates with poor survival outcomes in cancer patients,such as hepatocellular carcinoma(PMID: 33376525). Knockdown of FBL sensitizes tumor cells and xenografts to DNA crosslinking agents, and leads to homologous recombination-mediated DNA repair defects(PMID: 37489617).
实验方案
| Product Specific Protocols | |
|---|---|
| FC protocol for Fibrillarin antibody 66985-1-Ig | Download protocol |
| IF protocol for Fibrillarin antibody 66985-1-Ig | Download protocol |
| IHC protocol for Fibrillarin antibody 66985-1-Ig | Download protocol |
| IP protocol for Fibrillarin antibody 66985-1-Ig | Download protocol |
| WB protocol for Fibrillarin antibody 66985-1-Ig | Download protocol |
| Standard Protocols | |
|---|---|
| Click here to view our Standard Protocols |
发表文章
| Species | Application | Title |
|---|---|---|
Gastroenterology Nucleolar HEATR1 upregulated by mTORC1 signaling promotes hepatocellular carcinoma growth by dominating ribosome biogenesis and proteome homeostasis | ||
Mol Cell lncRNAs maintain the functional phase state of nucleolar prion-like protein to facilitate rRNA processing | ||
BMC Biol A pair of long intergenic non-coding RNA LINC00887 variants act antagonistically to control Carbonic Anhydrase IX transcription upon hypoxia in tongue squamous carcinoma progression | ||
Thorac Cancer LncRNA FAM83A-AS1 promotes lung adenocarcinoma progression by enhancing the pre-mRNA stability of FAM83A. | ||
STAR Protoc Protocol for investigating phase transition of prion-like proteins in vitro with concentration variation | ||
Cell Death Discov Protein expression of nucleolar protein 12 in the retina and its implication in protection of retina from UV irradiation damage |